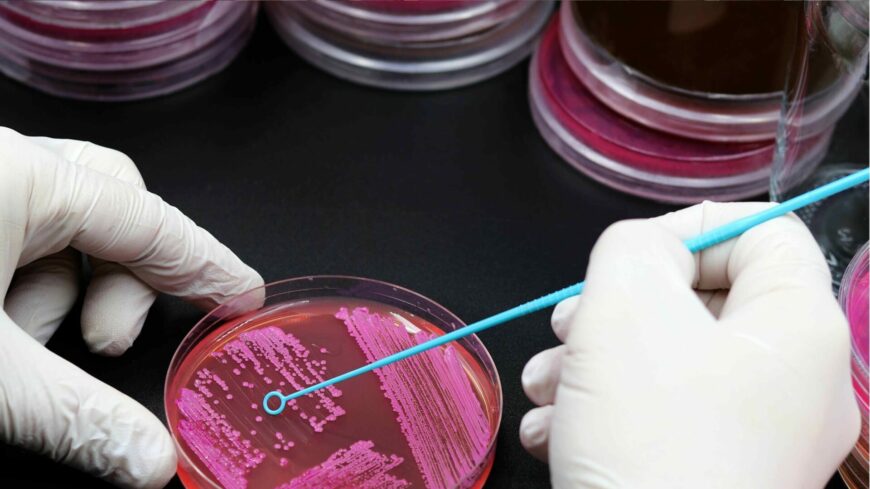

A Széchenyi István Egyetem Mosonmagyaróvári Albert Kázmér Karán indult el a
mikrobiológiai laboráns mikrokredit-képzés, amely gyorsan nagy érdeklődést váltott ki.
A program olyanok számára kínál betekintést a mikrobiológia precíz és összetett világába,
akik rendelkeznek érettségivel és vonzza őket a laboratóriumi szakmai munka.
A képzés gyakorlatias felépítése lehetővé teszi, hogy a résztvevők elsajátítsák a mintavétel, a steril
technikák, a tenyésztési eljárások és a mikroorganizmusok azonosításának alapjait.
A modern élelmiszer-, gyógyszer- és kutatólaborok számára nagy szükség van olyan
szakemberekre, akik magabiztosan mozognak a mikrobiológiai vizsgálatok területén.
A mikrokredit-képzés éppen ezt a speciális, azonnal használható tudást adja át, amely stabil
elhelyezkedési lehetőséget biztosít a laborok világában.
A program népszerűségét jól mutatja, hogy a december 4-i modul már teljesen betelt, így
arra már nincs lehetőség jelentkezni. A nagy érdeklődés egyértelműen jelzi, hogy a
Mosonmagyaróvári kar képzése valós igényre reagál, és fontos szerepet tölt be a
laboratóriumi utánpótlás biztosításában.